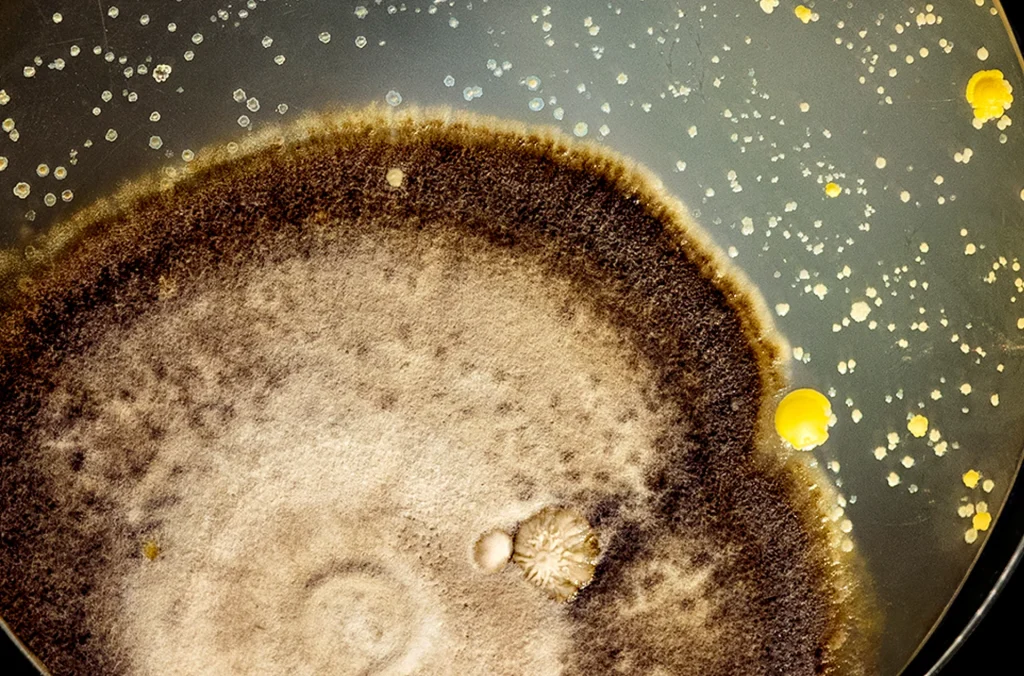

Bruna Mayer is GlogauAIR resident from March, 2018 to May, 2018 and from June, 2018 to September, 2018
Brazil
Meet the Artist
Coming soon
Statement
Within my artist practice, I develop my work through video, installation and currently, with living micro-organisms to explore the hidden and untamed facets of the self, that consolidate one’s existence. A pursue to connect with the most intimate parts of the being – through the body’s biological and non-physical dimensions. A search for underlying aspects, that might have been neglected or put aside, due to their unsettling characteristics, but that when denied, grow stronger, infiltrating and expanding under the surface. I use the notion of the body to reflect upon opposing topics such as internal and external, the visible and the obscure, desire and repulse.
GlogauAIR Project
Through a visual, temporal and spatial construction, Bruna creates an ambiguous encounter between the secluded and the unknown within, finding beauty in the most unexpected of places. Currently exploring and experimenting with living micro-organisms and the invisible ecosystem within the body – its undermined, natural and untamed existence, that makes up an essential part of life. Within enclosed containers, these invisible living creatures can grow and proliferate freely, while forming their own unique and uncontrollable patterns, as they spread and thus becoming visible to the viewer. Likewise, our innermost aspects – our impulses and primitive desires – also need to be nurtured and cultivated in a safe territory in order to exist freely, without neglect or fear, but rather, acceptance and assimilation with one’s self as they are our most dominant source of potency, creativity and strength. The work invites viewers to connect with their most intimate self and perhaps access neglected inner states.
CV Summary
b. 1986, Brazil
EDUCATION
- 2015 Bachelor of Fine Arts, Centro Universitario Belas Artes de Sao Paulo, BR.
- 2005 – 2009 Art Center College of Design – Illustration, Pasadena, USA.
- 2002 – 2005 Miami Dade College, Dual Enrollment in Visual Arts, Miami, USA.
GROUP EXHIBITIONS
- 2017 “Mostra Escola Entropica”, Instituto Tomie Ohtake, Sao Paulo, BR.
- 2017 “3a. Mostra B.A.” – Espaco Di Grado, Sao Paulo, BR.
- 2017 “Metanoia”, Coletiva AIREZ 2017, Airez Galery, Curitiba, BR.
- 2017 “(In)Possibilidades”, Incubadora de Artistas, Atibaia, BR.
- 2017 Arte Londrina 5 – “As Coisas se Escoram Tortas”, curated by Ricardo Basbaum e Danillo Villa, Divisao de artes Plasticas da Casa de Cultura/ UEL, Londrina, BR.
- 2017 “Mostra Escola Entropica”, Instituto Tomie Ohtake, Sao Paulo, BR.
- 2017 “Bienal Arte Print Brasil”, Incubadora de Artistas, Atibaia, BR.
- 2017 “Presenca Permeavel” – video installation and performance at Praca das Artes Fundacao Theatro Municipal de Sao Paulo, BR.
- 2017 “Salao Colecao de Verao”, Casa Da Xiclet, Sao Paulo, BR.
- 2017 Novas Poeticas, Virtual Gallery, Eixo Arte, BR.
- 2016 “Mostra Escola Entropica”, Instituto Tomie Ohtake, Sao Paulo, BR.
- 2016 Novas Poeticas, curated by Germano Dusha, Guilherme Gutman e Pollyana Quintella at Fundacao Museu do Futuro Curitiba, BR.
- 2016 “Tempo Suspenso”, curated by Luciano Mariussi e Leandro Roman, Galeria 13, Sao Paulo, BR.
- 2016 “Processos Criativos”, Wesley Duke Lee Art Institute, Sao Paulo, BR.
- 2015 Arte Londrina 4 – “Alguns Desvios do Corpo”, curated by Danillo Villa and Caue Alves, Casa de Cultura UEL, Londrina, BR.
- 2015 “Fragmentos da Memoria”, Galeria 13, Sao Paulo, BR.
- 2015 “Permissoes: Ruidos Poeticos”, Galeria 13, Sao Paulo, BR.
- 2015 “Olhar Grafico”, curated by Helena Freddi and Katia Salvany, MUBA Museu Belas Artes de Sao Paulo, BR.
- 2009 “Art and Dance show”, Complete Actor’s Place. Los Angeles, USA.
- 2009 November Group Show, The Hive Gallery, Los Angeles, USA.
- 2008 “The Women’s Show 3”, Cactus Gallery, California, USA.
- 2007 Exhibition organized by Instituto Paranaense de Arte, Centro Cultural Gilberto Mayer, Cascavel, BR.
- 2005 “Rising Stars”, NWSA Art Exhibition, Miami, USA.
JURY
- Juri Member of Novas Poeticas, Galeria Canizares, Salvador, BR. – 2017
GRANTS AND AWARDS
- 2015 Prize for Best Short-Film, Virgins Produced by Bruna Mayer and Victor Ribeiro, Los Angeles Brazilian Film Festival, USA.
FILM FESTIVALS
- 2015 Los Angeles Brazilian Film Festival, Los Angeles, USA.
- 2015 3a Mostra Cultura de Cinema Brasileiro, Fortaleza, BR.
- 2015 WHAT The Festival, Oregon, USA.
Gallery